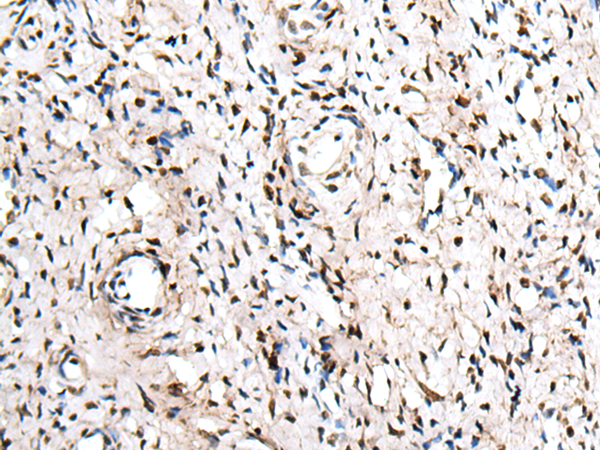

中文名稱:兔抗ZNF207多克隆抗體
技術(shù)規(guī)格
Background:
Zinc-finger proteins contain DNA-binding domains and have a wide variety of functions, most of which encompass some form of transcriptional activation or repression. The majority of zinc-finger proteins contain a Krüppel-type DNA binding domain and a KRAB domain, which is thought to interact with KAP1, thereby recruiting histone modifying proteins. ZNF207 (zinc finger protein 207) is a 478 amino acid protein that localizes to the nucleus and contains two C2H2-type zinc fingers. Expressed ubiquitously, ZNF207 may function as a transcription factor. Three isoforms of ZNF207 are expressed due to alternative splicing events.
Applications:
ELISA, WB, IHC
Name of antibody:
ZNF207
Immunogen:
Fusion protein of human ZNF207
Full name:
zinc finger protein 207
Synonyms:
BuGZ; hBuGZ
SwissProt:
O43670
ELISA Recommended dilution:
5000-10000
IHC positive control:
Human cervical cancer
IHC Recommend dilution:
25-100
WB Predicted band size:
51 kDa
WB Positive control:
HEPG2 and Hela cell lysates
WB Recommended dilution:
500-2000

購物車
幫助
021-54845833/15800441009
